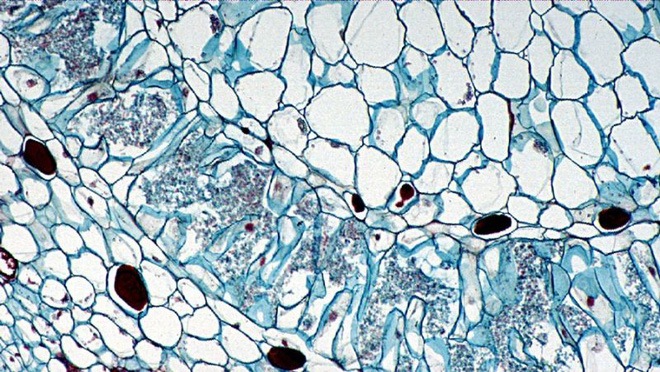
N-acyl-amit.jpg

Ngày nay, bạn có thể bắt gặp bất cứ đâu những tuyên bố về mối liên hệ giữa vi sinh vật đường ruột và sức khỏe, chẳng hạn như: Ăn sữa chua bổ sung vi sinh vật sẽ giúp bạn khỏe mạnh hơn. Cốm vi sinh giúp trẻ tăng sức đề kháng…
Nghiên cứu khoa học cũng chỉ ra vi khuẩn đường ruột có thể là nguyên nhân gây ra rối loạn não. Nhưng tất cả những hiện tường này chỉ mới là thứ chúng ta quan sát được. Còn giải thích hiện tượng đó như thế nào vẫn còn là một câu hỏi lớn.
Tại sao các vi sinh vật nhỏ bé trong ruột có thể gây ảnh hưởng lớn đến sức khỏe của chúng ta?
Mới đây, một nghiên cứu đăng trên tạp chí Nature đã bước đầu làm sáng tỏ được vấn đề. Theo đó, các nhà khoa học đến từ Đại học Rockefeller nói rằng :Vi khuẩn trong ruột chúng ta sản sinh ra những phân tử hóa học mang tín hiệu. Các phân tử này có thể tương tác với thụ thể người, gây ảnh hưởng lên các quá trình sinh học trong cơ thể.
Hiểu một cách đơn giản thì họ đã phát hiện ra cuộc trò chuyện hóa học giữa vi khuẩn và cơ thể. Nếu học được thứ ngôn ngữ này, chúng ta cũng có khả năng dùng nó để tác động tới sức khỏe, ví dụ như tăng giảm cân, lượng đường trong máu hay hơn nữa là chữa bệnh.
Phải khẳng định lại một lần nữa, đây là nghiên cứu chỉ ra mối quan hệ trực tiếp nhất giữa vi khuẩn đường ruột và sức khỏe.
Đầu năm, có một nghiên cứu đăng trên tạp chí Nature chứng minh rằng vi sinh vật đường ruột gây ảnh hưởng tới sức khỏe. Theo đó, sự rò rỉ một loại vi khuẩn sống trong áp xe ruột vào máu có thể là nguyên nhân gây ra chứng rối loạn não. Nếu được điều trị với kháng sinh, rối loạn não không xảy ra nữa.
Trước đây, nhiều nghiên cứu cũng gián tiếp chỉ ra mối liên quan giữa vi khuẩn đường ruột với nhiều loại bệnh như béo phì, tự kỷ và hội chứng hay lo lắng. Nhưng các kết quả này chưa chắc chắn và còn gây ra nhiều tranh cãi.
“Con người đã sắp xếp được trình tự gen của rất nhiều vi sinh vật cơ thể. Nó cho phép tôi tin rằng khi đặt vi khuẩn đường ruột của một người khỏe mạnh, bên cạnh những vi khuẩn của người có bệnh, tôi sẽ tìm ra những điểm khác nhau”, nhà sinh học phân tử Sean Brady, tác giả nghiên cứu mới cho biết.
Nhưng ngay cả khi Brady thực hiện được so sánh này, nó cũng chỉ là một quan sát. Cơ chế khiến vi khuẩn đường ruột gây ảnh hưởng tới sức khỏe vẫn là một bí ẩn.
Dựa vào suy đoán của mình, các nhà khoa học nghi ngờ vi khuẩn trong ruột có một con đường liên lạc với cơ thể, nhưng họ chưa biết con đường đó là gì. Trong tự nhiên, vi khuẩn thường tiết ra các phân tử nhỏ để tương tác với môi trường của chúng.
Một số nhà khoa học cho rằng vi sinh vật sống trong cơ thể người cũng làm điều tương tự để giao tiếp với vật chủ.
Vi khuẩn trong ruột người sản sinh N-acyl amit để giao tiếp với vật chủ
Bằng chứng của con đường giao tiếp này đã được nghiên cứu của Brady và đồng nghiệp chỉ ra. Theo đó, các nhà khoa học nhận thấy vi khuẩn trong ruột người sản sinh N-acyl amit. Đây là một phân tử nhỏ có khả năng tương tác với 5 thụ thể khác nhau của con người.
Trong thí nghiệm trên chuột, họ đã chứng minh tín hiệu N-acyl amit ảnh hưởng đến hai yếu tố là hoóc-môn chuyển hóa và glucose.
"Ít nhất, chúng ta đã tìm ra một cách mà các vi sinh vật sử dụng để giao tiếp với cơ thể, là chức năng truyền thông tin qua các phân tử nhỏ”, Brady nói. Đây là một phát hiện quan trọng mà sẽ sớm thu hút được cộng đồng khoa học tập trung nghiên cứu. Rồi mọi chuyện sẽ được làm sáng tỏ, những vi sinh vật bé nhỏ trong ruột làm thế nào có thể giúp chúng ta khỏe mạnh hay mắc bệnh?
Công bằng mà nói, nghiên cứu mới của Brady mới chỉ được thực hiện trong môi trường thí nghiệm và đối tượng thử nghiệm là chuột. Chúng ta vẫn chưa rõ tín hiệu này có hoạt động tương tự ở người, trong điều kiện bình thường hay không.
Nhưng Brady nói, nếu điều đó là sự thật, những tín hiệu phân tử này mang rất nhiều ý nghĩa:
"Nhìn lại lịch sử, chúng ta đã có thể chữa trị cho con người bằng các phân tử nhỏ (ví dụ như phân tử thuốc). Có thể, chúng ta sẽ tiếp tục làm được điều tương tự với vi sinh vật. Một khi đã hiểu chúng giao tiếp với cơ thể như thế nào, bạn có thể tìm cách làm gián đoạn giao tiếp đó nhằm mục đích chữa bệnh".
Nói cách khác, để điều trị bệnh của ai đó, bạn có thể làm bằng cách dạy vi khuẩn phát tín hiệu đúng để khắc phục sai hỏng trong cơ thể họ. Bạn cũng có thể ăn vào một loại vi khuẩn để làm giảm cân và đường trong máu, Brady nói. "Điều này quả thật rất tuyệt".
Tham khảo Trithuctre/Gizmodo